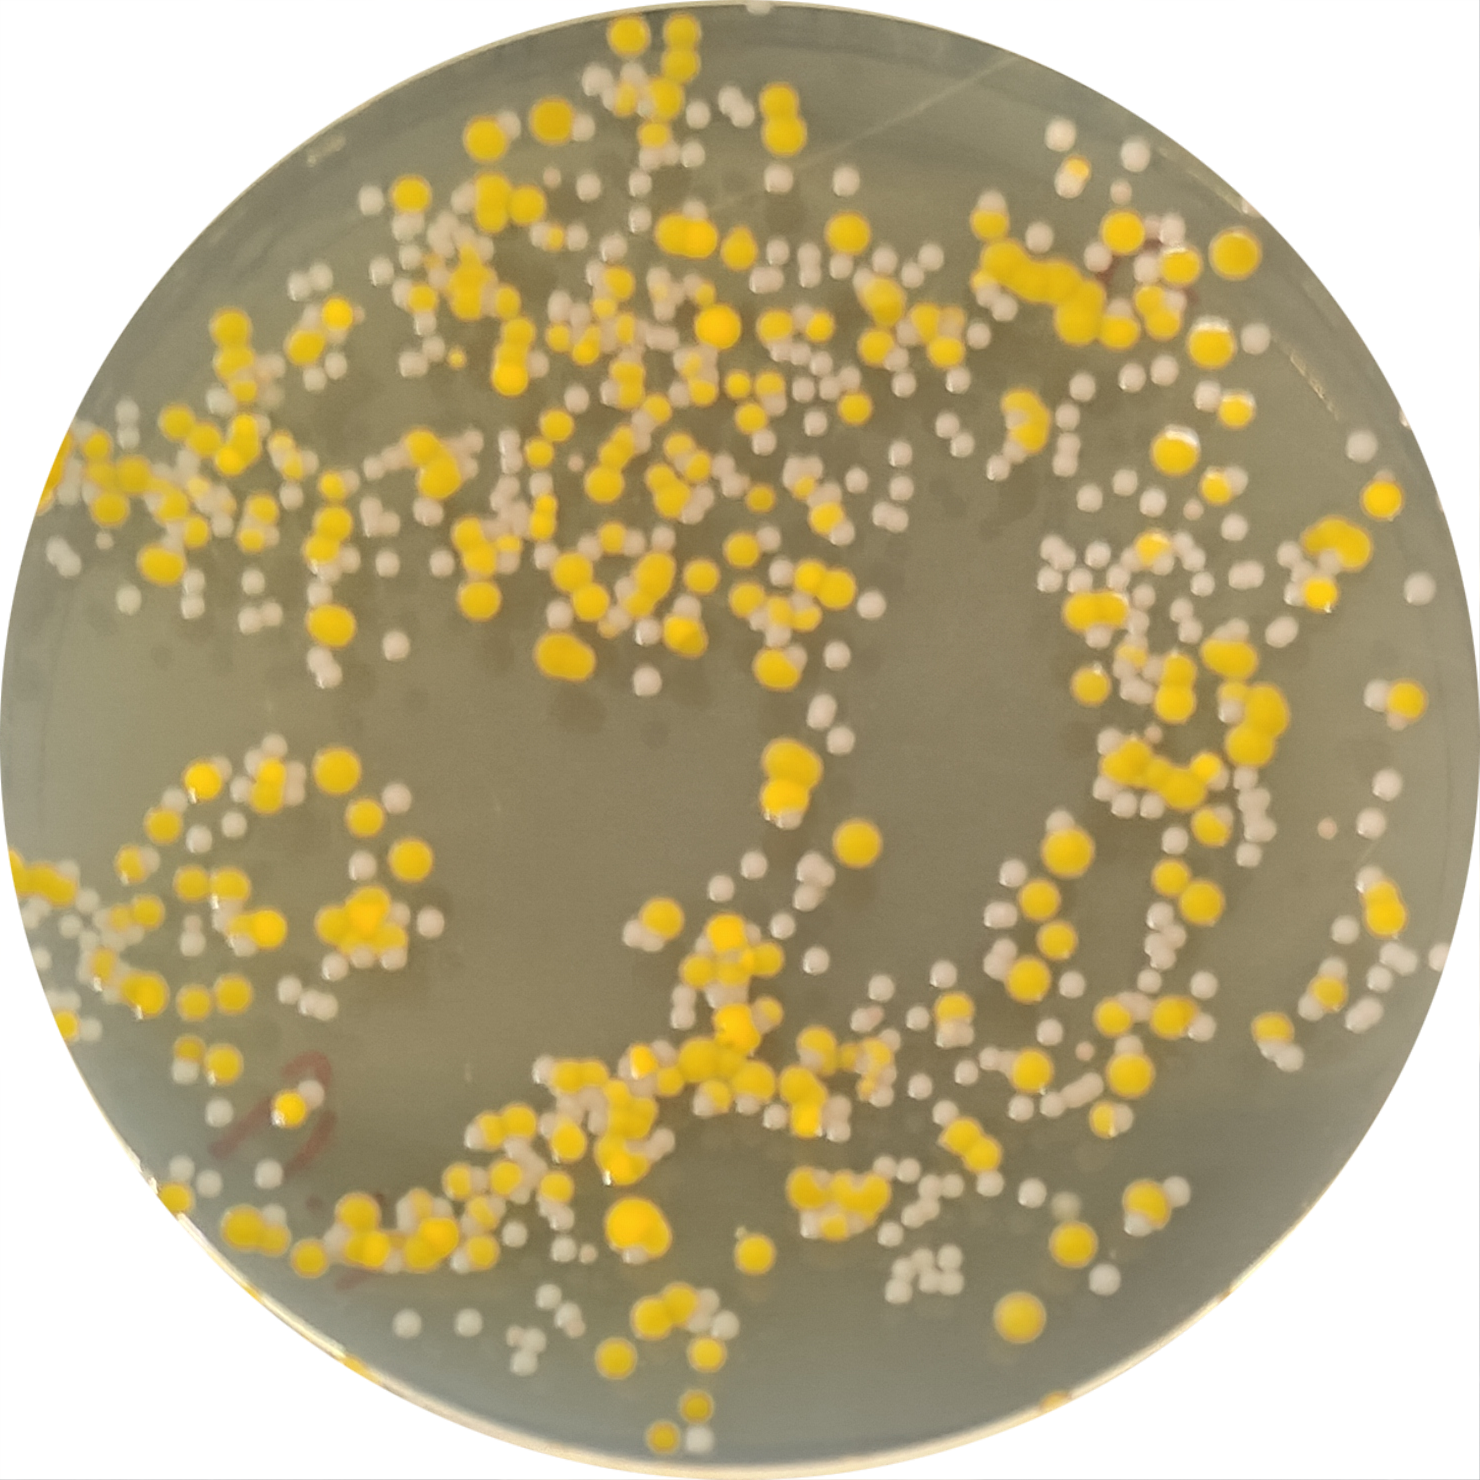
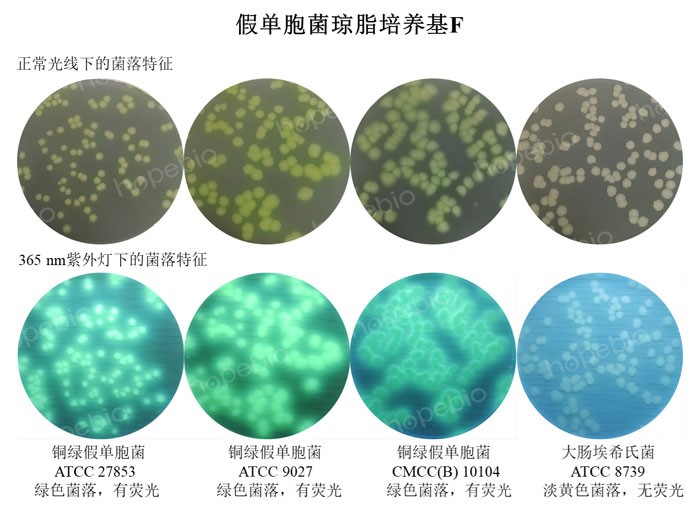

海博微信公众号
海博微信公众号
 海博天猫旗舰店
海博天猫旗舰店


 海博微信公众号
海博微信公众号
 海博天猫旗舰店
海博天猫旗舰店




一.微观世界的奇迹
在我们脚下的土壤中,在我们呼吸的空气中,在我们饮用的水中,甚至在我们自己的身体里,存在着一个肉眼无法看见的神秘世界。这个世界的居民——微生物,是地球上最古老、最多样、数量最庞大的生命形式。它们的个体微小到需要用显微镜才能观察,但它们的集体力量却塑造了整个地球的生态系统。
如果我们能缩小到微生物的尺度,我们将会看到一个令人惊叹的“花海世界”。在这个世界里,细菌如同五彩斑斓的花朵,真菌菌丝编织成壮丽的地下网络,病毒则像精致的艺术品悬浮在空中。这个微观世界不仅美丽绝伦,还充满了智慧和奇迹,等待我们去探索和发现。正如一滴水中的微生物世界,宛如一个色彩斑斓的微型花园。在这个花园里,各种微生物相互依存、相互作用,构成了一个复杂而和谐的生态系统。图1左为涂布100 μL的取样水于营养琼脂平板(货号:HB0109)上培养48 h的结果,图中具有多种形态特征的菌落。图1右为模拟图,表示一滴水中便具有形形色色的菌株。
|
 |
|
图1 水世界中的微生物(左图为实图,右图为虚拟图) |
|
二.微生物的形态之美
微生物展现出惊人的形态多样性,从球菌的完美球形,到杆菌的规则柱体,再到螺旋菌的优雅螺旋,每一种形态都体现了数学与物理规律在生命中的完美呈现,如金黄色葡萄球菌、大肠埃希氏菌分别为球型、短杆状,革兰氏染色图如图2所示。海博革兰氏染色液试剂盒货号为HB8278。
 |
 |
|
图2 革兰氏染色图 |
|
当微生物聚集成群体时,它们展现出令人惊叹的自组织能力。细菌生物膜的三维褶皱结构、黏菌觅食时构建的网络,以及放线菌形成的菌丝网络,都体现了微生物群体的协作智慧和美学价值。
微生物的形态之美不仅体现在单个细胞的结构上,还体现在它们的群体行为中。例如,某些细菌在生长过程中会形成复杂的菌落图案,这些图案不仅美丽,还反映了细菌之间的通信和协作机制。例如图3,这是我们在培养霉菌过程中偶然发现的图案。最近的研究发现,这些微生物群体行为中蕴含着复杂的数学规律,如分形几何和混沌理论,为我们理解生命的复杂性提供了新的视角。

图3 培养霉菌平板上的图案
随着显微技术的不断进步,我们对微生物形态的认识也在不断深入。冷冻电镜、超分辨率显微镜等新技术的应用,让我们能够观察到纳米尺度下微生物的精细结构,如某些古菌表面的蛋白晶格结构,其复杂度甚至超越了人工设计的纳米材料。这些发现不仅拓展了我们对生命多样性的认识,也为材料科学和纳米技术提供了新的灵感。
三.微生物的色彩艺术
许多微生物能产生绚丽的天然色素,如铜绿假单胞菌、藤黄微球菌、金黄色葡萄球菌在营养琼脂或胰蛋白胨大豆琼脂平板(货号:HB0177)上分别为绿色、鲜黄色、金黄色或白色,如图4所示。这些色素不仅为微生物提供了保护,还为自然界增添了丰富的色彩。
 |
 |
|
铜绿假单胞菌 |
藤黄微球菌 |
 |
|
|
金黄色葡萄球菌 |
|
图4 不同菌在琼脂平板上表现不同颜色
在特定条件下,某些微生物会发出迷人的荧光,如博兹曼军团菌、铜绿假单胞菌分别在BCYE琼脂基础(货号:HB8493)、假单胞菌琼脂培养基F(HB8445)上生长后,使用365 nm紫外灯照射能见到荧光,如图5所示。此外,某些海洋微生物,如费氏弧菌,能够通过群体感应机制同步发光,形成壮观的生物发光现象。这种发光不仅美丽,还在生物学研究和生物技术应用中具有重要价值。

图5 菌株在特定情况下产荧光示例(上图为博兹曼军团菌,下图为铜绿假单胞菌)
微生物的色彩艺术不仅体现在静态的色素上,还体现在动态的代谢过程中。例如,某些细菌在代谢过程中会产生具有特定颜色的代谢产物,这些产物的颜色会随着环境条件的变化而变化,形成一种动态的色彩艺术。最近的研究发现,这些色彩变化不仅美观,还反映了微生物的代谢状态和环境适应能力。
微生物的色彩艺术不仅具有美学价值,还在实际应用中发挥着重要作用。例如,某些微生物产生的天然色素已被广泛应用于食品工业和化妆品行业,取代了可能对人体健康有害的人工合成色素。此外,科学家还利用微生物的色彩变化来监测环境污染物的浓度,开发出了一种新型的生物传感器。
四.生态系统的隐形工程师
微生物虽然个体微小,却是生态系统的重要组成部分。它们参与了地球上几乎所有的生物地球化学循环,包括碳循环、氮循环、硫循环等。通过分解有机物、固氮、产甲烷等过程,微生物在维持生态平衡和全球气候变化中发挥着关键作用。微生物分解动植物残体和有机物,将大分子物质转化为小分子物质,完成生态系统的物质循环;蓝藻、光合细菌等微生物通过光合作用或化能合成作用,为食物链提供初始能量;微生物与动植物形成共生关系,如根瘤菌与豆科植物的固氮共生,肠道菌群与动物的共生等。
微生物的群体智慧不仅体现在生态系统层面,还体现在它们的社会行为中。例如,某些细菌能够通过群体感应机制进行细胞间通信,协调群体行为。当细菌密度达到一定阈值时,它们会同步表达特定基因,实现群体行为,如生物发光、生物膜形成等。这种群体行为不仅展示了微生物的协作智慧,还为我们理解生命的社会性提供了新的视角。
近年来,科学家发现微生物群体中存在着复杂的社会结构和分工合作。例如,某些细菌在生物膜中会形成不同的功能区域,类似于多细胞生物的组织器官。这种结构不仅提高了微生物群体的生存能力,还为我们理解多细胞生物的起源和进化提供了重要线索。
五.展望
生物的花海世界是一个充满奇迹和美丽的微观宇宙。在这个世界里,我们看到了生命的多样性和适应性,感受到了自然界的智慧和创造力。微生物虽然微小,但它们的影响却深远而广泛,它们塑造了地球的生态系统,影响着人类的健康和生活。
随着科学技术的不断进步,我们对微生物世界的认识也在不断深入。从普通光学显微镜到超分辨率显微镜,从传统培养技术到宏基因组学,每一项新技术的应用都为我们揭示了微生物世界的新奥秘。
六.更多精彩图片及产品罗列
我公司定期更新更多菌株精彩特征图片,可查阅:微生物特征图库 点击查看
本文涉及到的相关产品内容样式罗列如表1所示。
表1 相关产品示例
|
产品名称 |
货号 |
产品样式 |
|
革兰氏染色液试剂盒 |
HB8278 |
|
|
干粉培养基(示例营养琼脂) |
HB0109 |
|
上一篇:微生物在生态系统中的主要作用
下一篇:没有了!
| 相关文章: | ||



